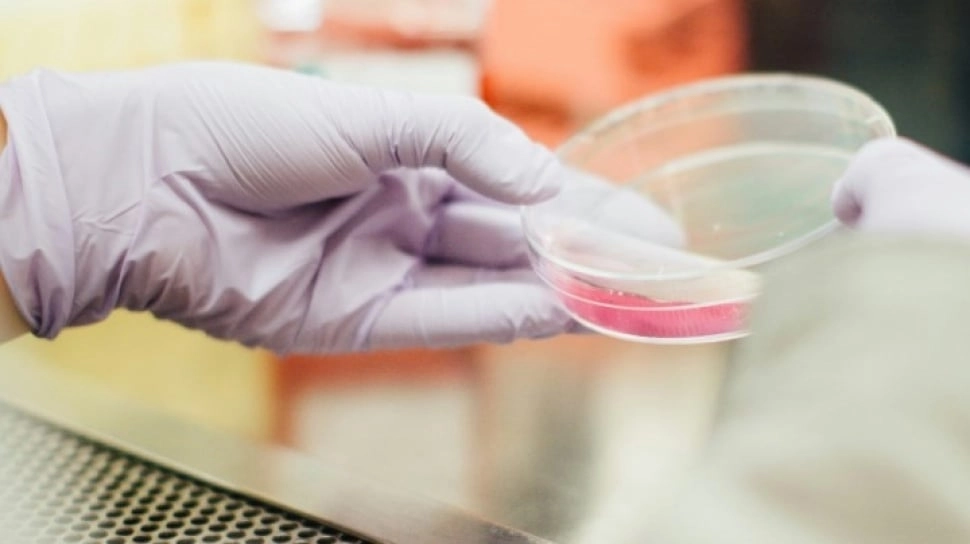
Semax: A Multifunctional Peptide and Its Potential Implications in Research

Semax: A Multifunctional Peptide and Its Potential Implications in Research
Semax, a heptapeptide analog of the adrenocorticotropic hormone (ACTH), has garnered attention for its intriguing properties and potential implications in various fields of research. Originally synthesized in Russia in the 1980s, Semax was developed with a primary focus on modulating the nervous system. Since its creation, researchers have increasingly explored its potential to influence molecular and cellular mechanisms. Some of these studies have produced results that hint at the peptide’s possible roles in neuroprotection, support for cognitive function, and even systemic maintenance of homeostasis.
While much of the focus remains on its impact on neurophysiological processes, there is growing curiosity about its broader implications across diverse biological systems. This article aims to explore Semax's various implications in research, with emphasis on its biochemical interactions and possible mechanisms. The peptide's potential to modulate molecular pathways suggests it may offer promising directions for future studies in multiple fields, ranging from neuroscience to regenerative studies.
Semax Peptide: Molecular Structure and Mechanisms
Semax is a synthetic derivative of ACTH, yet its structural modifications grant it distinct properties. Studies suggest that the removal of certain amino acids from the ACTH sequence may allow Semax to interact with a variety of biological systems in ways that the original hormone does not. While ACTH typically interacts with melanocortin receptors, Semax appears to have additional binding targets, particularly in the central nervous system (CNS). This may suggest that the peptide might influence various signaling pathways that regulate neurological processes, including neurogenesis, synaptic plasticity, and cognitive functioning.
It has been hypothesized that Semax may act as a modulator of the brain-derived neurotrophic factor (BDNF) pathway, which is integral for the survival and growth of neurons. Research indicates that the peptide may also influence neurotransmitter levels, such as dopamine and serotonin, indicating a potential for impacting emotional and behavioral regulation, as well as other cognitive processes like learning and memory.
Additionally, preliminary research indicates that Semax might be involved in regulating oxidative stress, providing a possible avenue for exploring its neuroprotective properties. Given these possibilities, the peptide is often speculated to hold significant promise in neurodegenerative research, potentially paving the way for new insights into conditions such as Alzheimer's disease or Parkinson's disease.
Semax Peptide: Cognitive Research
Cognitive function and support are believed to be primary areas in which Semax has gained attention. Research suggests that the peptide may play a role in supporting memory and learning, possibly through modulating neuroplasticity. Neuroplasticity refers to the brain's capacity to reorganize itself by creating new neural links throughout the lifespan of the brain. This process is essential for learning and memory across all multicellular species. Investigations purport that Semax's involvement in this process might make it an interesting candidate for exploring interventions aimed at supporting cognitive performance in both functional and declining research models.
Researchers have theorized that the peptide may increase the availability of BDNF, a neurotrophin critical for brain plasticity, synaptic modulation, and long-term potentiation—an essential mechanism for learning and memory. Investigations into the relationship between Semax and cholinergic neurotransmission also suggest that the peptide might influence acetylcholine levels, another key neurotransmitter involved in attention, learning, and memory.
Semax Peptide: Neuroscience
Semax has been widely discussed in the context of neuroprotection and neural recovery, suggesting its potential relevance for traumatic brain injury (TBI), stroke, and other neurological disorders. Findings imply that the peptide may have the potential to support recovery mechanisms in neurons by promoting the survival of neural cells under stress conditions. This function may be particularly valuable in ischemic conditions, where neurons are deprived of oxygen and nutrients, leading to cell death.
Researchers have also postulated that Semax might play a role in supporting neurogenesis, the process by which new neurons are created from neural stem cells. This has led to speculation about its possible implication in regenerative studies, where the potential to promote the formation of new neural cells is of paramount importance in recovery from injury or degenerative diseases.
Semax Peptide: Stress and Immunity
The hypothalamic-pituitary-adrenal (HPA) axis plays a paramount role in stress regulation, and data suggest that Semax may interact with this system. ACTH, from which Semax is derived, is a key component of the HPA axis and regulates cortisol release. While Semax lacks the full functionality of ACTH, research indicates that it might still influence this stress-regulating axis, possibly by affecting neuroendocrine pathways that govern responses to stress.
Semax Peptide: Ophthalmology
In addition to its cognitive and neuroprotective implications, Semax has also been explored in the field of ophthalmology. It has been suggested that the peptide may possess properties that might protect retinal cells from oxidative damage, which is often implicated in degenerative diseases that impact vision, such as glaucoma and macular degeneration. Due to its high metabolic activity, retinal tissue is highly susceptible to oxidative stress, making it a vulnerable target for degenerative diseases.
Semax Peptide: Future Directions and Considerations
The diverse biochemical properties of Semax position it as a fascinating candidate for ongoing research across multiple scientific disciplines. While much of the current investigation centers on its impact on the nervous system, its potential role in immune modulation, retinal protection, and cellular regeneration raises exciting questions about its broader implications.
The peptide's potential to modulate various molecular pathways, particularly those involved in neuroprotection and support for cognitive function, suggests it may offer significant insights into fundamental biological processes and disease mechanisms. Click here to visit Biotech Peptides, where licensed professionals can purchase Semax peptides as well as many other qualitative research compounds.
Tag: #semax #multifunctional #peptide #potential #implications #research










